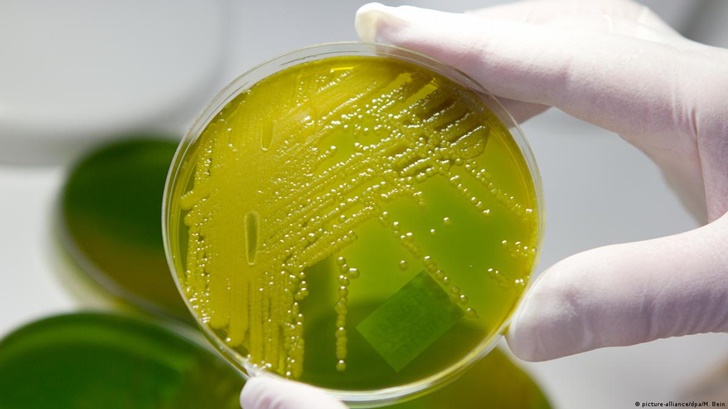
বাংলাদেশে ভয়াবহ আকার ধারণ করছে ‘সেপসিস’

বাংলাদেশে ভয়াবহ আকার ধারণ করছে ‘সেপসিস’
আক্রান্ত ৫০ শতাংশেরই মৃত্যু
যুগান্তর প্রতিবেদন
প্রকাশ: ১০ এপ্রিল ২০২৩, ১২:০০ এএম
প্রিন্ট সংস্করণ
|
ফলো করুন |
|
|---|---|
বিশ্বের বিভিন্ন দেশের মতো বাংলাদেশেও ভয়াবহ আকার ধারণ করছে সেপসিস নামক রোগ। এতে আক্রান্ত হলে ব্যাকটেরিয়া (জীবাণু) রক্তের কার্যক্ষমতাকে সম্পূর্ণভাবে পরাজিত করে। এর ভয়াবহ আরেকটি দিক হলো একে শনাক্ত করা বেশ কঠিন। এ কারণে সেপসিস গুপ্তঘাতক হিসাবেও পরিচিতি পেয়েছে বলে জানিয়েছেন চিকিৎসা বিশেষজ্ঞরা। তাদের মতে, সেপসিসে আক্রান্ত হলে প্রায় ৫০ শতাংশ রোগীই মৃত্যুবরণ করেন।
রোববার বঙ্গবন্ধু শেখ মুজিব মেডিকেল বিশ্ববিদ্যালয়ে সেন্ট্রাল সেমিনার সাব-কমিটির উদ্যোগে রক্তদূষণ, জীবাণুদূষণ বা রক্তে বিষক্রিয়া সেপসিস নিয়ে আয়োজিত সেমিনারে এসব তথ্য জানানো হয়েছে।
চিকিৎসকরা জানান, জীবাণুদূষণ বা ইংরেজিতে সেপসিস হলো খুব মারাত্মক অসুস্থতা। শরীরের একটি সংক্রমণ প্রতিরোধে শরীর অনেক বেশি প্রতিক্রিয়াশীল হয়ে উঠলে সেপসিস হয়। রক্তদূষণের এ রোগে বিশ্বজুড়ে পাঁচজনের একজন মৃত্যুবরণ করেন। এটি রক্তের বিষ হিসেবেও পরিচিত।
গবেষণায় দেখা গেছে, বিশ্বে সেপসিস আক্রান্ত হয়ে বছরে ১ কোটি ১০ লাখ মানুষ মারা যাচ্ছেন। এ সংখ্যা ক্যানসারে আক্রান্ত হয়ে মৃত্যুর সংখ্যার চাইতেও বেশি। সেপসিসে সবচেয়ে বেশি আক্রান্ত হন দরিদ্র এবং মধ্যম আয়ের দেশের মানুষ। শতাংশের হিসাবে যা প্রায় ৮৫ শতাংশ। সবচেয়ে ঝুঁকির মধ্যে রয়েছে শিশুরা। পাঁচ বছরের কম বয়সি দশজন শিশুর মধ্যে চারজনের সেপসিসে আক্রান্ত হওয়ার ঝুঁকি থাকে। সেমিনারে প্রধান অতিথি হিসাবে বক্তব্য রাখেন বিশ্ববিদ্যালয়ের উপাচার্য অধ্যাপক ডা. মো. শারফুদ্দিন আহমেদ। তিনি এ রোগের বিষয়ে জনসচেতনতা বৃদ্ধি, রোগ প্রতিরোধ ও গবেষণার ওপর গুরত্বারোপ করেন। তিনি বলেন, সেপসিসে আক্রান্ত রোগীর ফুসফুস কিডনিসহ বিভিন্ন অঙ্গপ্রত্যঙ্গ অকার্যকর করে দেয়। বৈজ্ঞানিক প্রবন্ধে বলা হয়, জীবাণুদূষণ খুবই মারাত্মক অসুস্থতা যার মাধ্যমে জীবাণু রক্তে ছড়িয়ে পড়ে। রক্তের কোষগুলোর কার্যক্ষমতা সম্পূর্ণ লোপ পায়। এটি দেহের প্রধান অঙ্গসমূহ যেমন-যকৃৎ, বৃক্ক (কিডনি), হৃৎপিণ্ড, ফুসফুস, মস্তিষ্ক, অস্ত্র, অ্যাড্রেনাল গ্রন্থিকে সংক্রমিত করে। বিশেষ করে যাদের রোগ প্রতিরোধ ক্ষমতা কম, দীর্ঘমেয়াদি অসুস্থতা আছে বা মাল্টি ড্রাগ রেজিস্ট্যান্স জীবাণুর দ্বারা সংক্রমিত রোগীর দ্রুত অবস্থার অবনতি ঘটে।
সেমিনারে বলা হয়, জীবাণু রক্তে প্রবেশের পর মানবদেহে অনেক পরিবর্তন পরিলক্ষিত হয়। জীবাণুর কোষপ্রাচীরের অংশ মানবদেহের রক্তনালির কোষ, মনোসাইট এবং নিউট্রোফিলকে সক্রিয় করে। বিক্ষত-প্রদাহপূর্ব সাইটোকাইন নিঃসরণ করে। ফলে রক্ত জমাট বাঁধার প্রক্রিয়া ত্বরান্বিত ও রক্তচাপ কমে যায়। টিস্যু ওডিমা হয়। ক্ষুদ্র রক্তনালিতে থ্রম্বোসিস হয়। ফলাফলস্বরূপ অঙ্গ ও অন্ত্রসমূহে অর্গান ফেইলর হয়। শেষ পর্যন্ত রোগীর সেপটিপসিম ডেভেলপ করে। রোগীকে নিবিড় পরিচর্যা কেন্দ্রে ভর্তি করাতে হয় এবং শতকরা প্রায় ৫০ শতাংশ মৃত্যুবরণ করেন।
চিকিৎসকরা বলেন, মানুষের রোগ প্রতিরোধ ক্ষমতা অতিরিক্ত কাজ করার ফলে সেপসিস হতে পারে। এ প্রতিরোধ ক্ষমতা কেবল সংক্রমণের বিরুদ্ধে লড়াই করার পরিবর্তে শরীরের অন্য অংশগুলোতেও আক্রমণ শুরু করে। এক পর্যায়ে মানুষের অঙ্গ অকেজো হয়ে যায়। এমনকি বেঁচে থাকা মানুষদেরও দীর্ঘমেয়াদি ক্ষতি ও অক্ষমতা নিয়ে চলতে হতে পারে। যেসব ব্যাকটেরিয়া এবং ভাইরাসের কারণে ডায়রিয়া সংক্রমণ বা ফুসফুসের রোগ হয়ে থাকে সেগুলোই সেপসিস হওয়ার সবচেয়ে বড় কারণ। সেপসিসে আক্রান্ত ব্যক্তির হার্ট রেট স্বাভাবিকের চাইতে বেশি হয়।
প্রতিরোধ প্রসঙ্গে তারা বলেন, অনেক দেশের ক্ষেত্রে সেপসিস প্রতিরোধের উপায় হলো সুষ্ঠু পয়ঃনিষ্কাশন ব্যবস্থা, বিশুদ্ধ পানি এবং সঠিক সময় সঠিক টিকার জোগান। অন্যান্য চ্যালেঞ্জের মধ্যে একটি হলো, দেরি হওয়ার আগেই সেপসিস আক্রান্ত রোগীদের ভালোভাবে চিহ্নিত করা এবং দ্রুত তাদের চিকিৎসা শুরু করা। এছাড়া অ্যান্টিবায়োটিক বা অ্যান্টি-ভাইরাসের মাধ্যমে প্রাথমিক চিকিৎসা শুরু করলে সংক্রমণ প্রতিরোধ করা সম্ভব।
